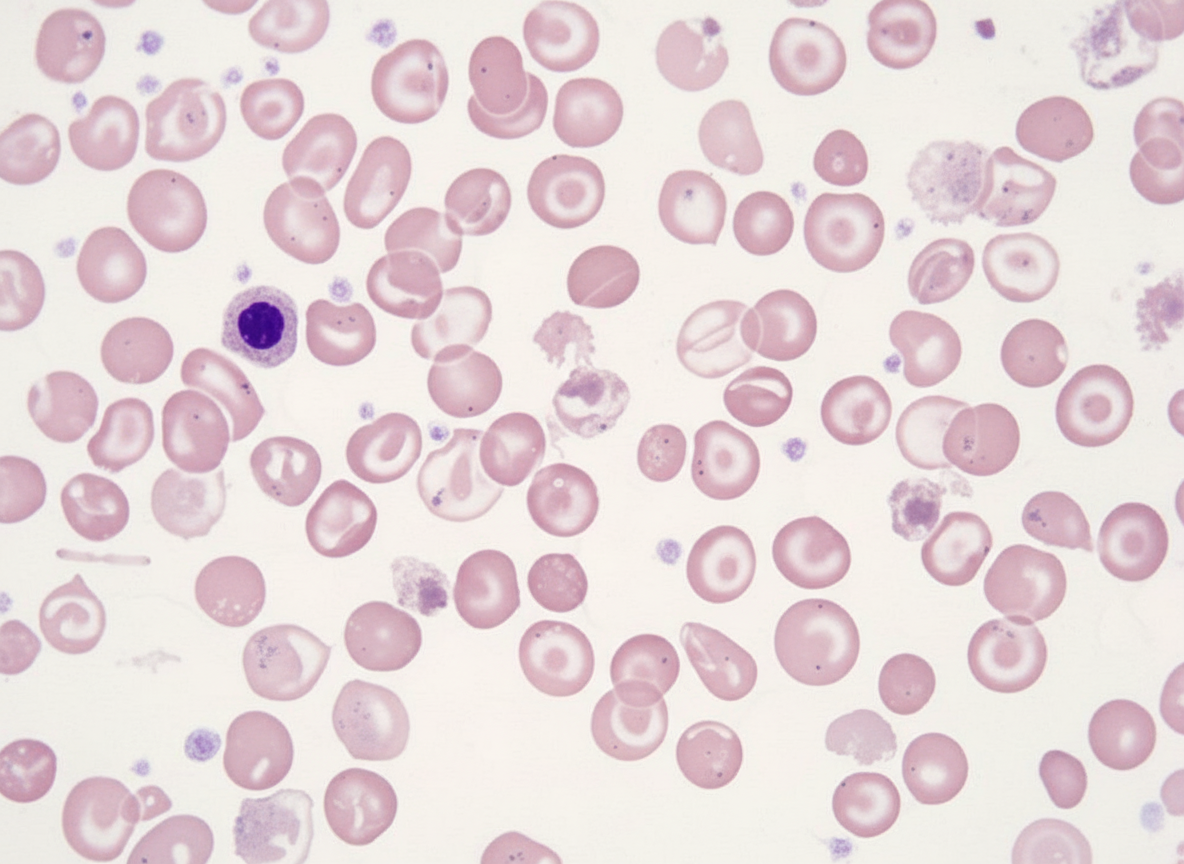
Image for question 152

Which of the following is NOT related to fetal erythropoiesis?
A 5-year-old male child presents with severe transfusion-requiring anemia and jaundice. On examination, the liver and spleen are palpable 5 cm below the costal margin. Peripheral smear analysis shows findings consistent with a specific diagnosis. What is your diagnosis?
What is the first change of improvement noted after iron therapy is initiated?
A 7-year-old boy presented with sudden onset petechiae and purpura. There was a history of upper respiratory tract infection 2 weeks prior. On examination, there was no hepatosplenomegaly. What is the most probable diagnosis?
A 20-month-old female child presents for a routine check-up. A complete blood count (CBC) reveals moderate neutropenia, but the child appears healthy, eats well, and is within expected developmental parameters for her age and sex. Other blood count parameters are within the normal range for her age. The family history is unremarkable. Repeat CBCs after one and two weeks show persistent neutropenia. Bone marrow examination is normal. What is the next best step in management?
Macrocytic anemia in children is produced by all of the following except?
A 5-year-old boy presents with petechial spots that appeared overnight. Two weeks prior, he experienced abdominal pain. There is no hepatosplenomegaly. What is the most likely diagnosis?
A 6-week-old child presents with a hemoglobin of 10 gm% and appears pale on examination. What is the most likely diagnosis?
Frameshift mutation occurs due to:
A 2-year-old child presents with short stature and cafe-au-lait spots. Bone marrow aspiration yields a little material and mostly containing fat. What is your diagnosis?
Explanation: The question asks to identify which statement is **NOT** related to fetal erythropoiesis. However, based on standard medical embryology, **Option A is actually a correct statement**, making the question likely a "negative stem" error or requiring the identification of the most accurate timeline. In NEET-PG, understanding the chronological shift of hematopoiesis is high-yield. ### **Explanation of Options** * **Option A (Correct Fact):** Erythropoiesis begins in the **mesoderm of the yolk sac** (Mesoblastic stage) at approximately the 3rd week of gestation. This is the first site of blood cell production. * **Option B (Incorrect Statement/The "Not Related" Fact):** This is the incorrect statement because the **liver** becomes the major site of erythropoiesis much earlier, around the **2nd trimester (peak at 3–5 months)**. By the 20th week (5 months), the bone marrow is already beginning to take over as the primary site. * **Option C (Correct Fact):** During the 3rd trimester (around 28–30 weeks), the **bone marrow** (Myeloid stage) becomes the definitive and primary site of hematopoiesis, which continues throughout postnatal life. * **Option D (Correct Fact):** At birth (term), **75–80%** of the total hemoglobin is **Fetal Hemoglobin (HbF: α2γ2)**, which has a higher affinity for oxygen. The remainder is Adult Hemoglobin (HbA: α2β2). ### **High-Yield Clinical Pearls for NEET-PG** * **Chronology Mnemonic:** **"Young Liver Synthesizes Blood"** (Yolk sac → Liver → Spleen → Bone marrow). * **HbF Transition:** HbF levels drop rapidly after birth, being replaced by HbA, usually reaching adult levels (<1%) by 6–12 months of age. * **Site of Erythropoietin:** In the fetus, erythropoietin is primarily produced in the **liver**; after birth, the **kidneys** take over this role.
Explanation: ***Thalassemia*** • **Microcytic hypochromic RBCs**, **target cells**, **nucleated RBCs**, and **poikilocytosis** on peripheral smear are pathognomonic for thalassemia major in a young child with severe anemia. • **Massive hepatosplenomegaly** (5 cm below costal margin) occurs due to **extramedullary hematopoiesis** and **iron overload**, characteristic of thalassemia major requiring regular transfusions. *Nutritional anemia* • Would typically present as **iron deficiency** with **microcytic hypochromic** RBCs but without **target cells** or **nucleated RBCs** on peripheral smear. • Does not cause **massive hepatosplenomegaly** or require **frequent transfusions** in early childhood. *Aplastic anemia* • Characterized by **pancytopenia** with **hypocellular bone marrow**, not isolated severe anemia with abnormal RBC morphology. • Peripheral smear shows **normocytic normochromic** RBCs without the characteristic findings of **target cells** or **nucleated RBCs**. *Autoimmune hemolytic anemia* • Would show **spherocytes** and **polychromasia** on peripheral smear, not the **microcytic hypochromic** pattern with **target cells**. • Typically responds to **immunosuppressive therapy** rather than requiring chronic transfusions from early childhood.
Explanation: **Explanation:** The clinical response to iron therapy in Iron Deficiency Anemia (IDA) follows a highly predictable chronological sequence. **1. Why "Decreased Irritability" is correct:** The earliest response to iron therapy is **subjective clinical improvement**, specifically a decrease in irritability and an increase in appetite. This occurs within **12 to 24 hours** of initiating therapy. This rapid change happens because iron is a crucial cofactor for several enzymes in the central nervous system (such as monoamine oxidase) and cellular metabolism (cytochromes). These enzymes are replenished long before new red blood cells are produced. **2. Analysis of Incorrect Options:** * **B. Reticulocytosis:** This is the first **objective hematological** sign of improvement. It typically begins within 48–72 hours and peaks between 5 to 10 days after starting therapy. * **C. Increase in serum iron levels:** While serum iron may fluctuate after a dose, it is not used as a reliable marker of early therapeutic response compared to clinical or reticulocyte changes. * **D. Replenishment of iron stores:** This is the **final** stage of therapy. Hemoglobin levels usually normalize within 1–2 months, but therapy must be continued for an additional 3–4 months to replenish ferritin (iron stores). **High-Yield Clinical Pearls for NEET-PG:** * **Sequence of Improvement:** Subjective/Enzymatic (12-24h) → Reticulocytosis (3-7 days) → Increase in Hemoglobin (begins in 1 week, normalizes by 2 months) → Storage/Ferritin (3-6 months). * **Oral Dose (Pediatrics):** 3–6 mg/kg/day of elemental iron. * **Best Absorption:** Iron is best absorbed on an empty stomach with Vitamin C (ascorbic acid), which maintains iron in the ferrous ($Fe^{2+}$) state.
Explanation: ### Explanation The clinical presentation is classic for **Immune Thrombocytopenic Purpura (ITP)**, formerly known as Idiopathic Thrombocytopenic Purpura. **Why Option C is Correct:** ITP in children typically presents in the **2–8 year age group** with a sudden onset of isolated thrombocytopenia (petechiae, purpura, and bruising). A key diagnostic feature is a **preceding viral illness** (URTI or exanthem) occurring 1–3 weeks prior. Crucially, the absence of hepatosplenomegaly and lymphadenopathy points toward a diagnosis where only the platelet lineage is affected, rather than a systemic or bone marrow process. **Why Other Options are Incorrect:** * **A. Acute Lymphoblastic Leukemia (ALL):** While ALL presents with petechiae, it is usually accompanied by systemic signs like fever, bone pain, and physical findings like **hepatosplenomegaly** or lymphadenopathy. * **B. Acute Viral Infection:** While some viruses (like Dengue) cause thrombocytopenia, the 2-week lag period and the "sudden onset" of skin bleeds in an otherwise well-appearing child specifically favor the post-viral immune-mediated destruction seen in ITP. * **D. Aplastic Anemia:** This involves pancytopenia. Patients would typically present with symptoms of anemia (pallor, fatigue) and increased susceptibility to infections (neutropenia), which are absent here. **Clinical Pearls for NEET-PG:** * **Pathogenesis:** Type II hypersensitivity reaction where IgG autoantibodies are directed against platelet surface glycoproteins (**GpIIb/IIIa**). * **Bone Marrow:** If performed (to rule out leukemia), it shows **increased megakaryocytes**. * **Management:** Most childhood cases are self-limiting. If treatment is required (platelets <20,000/mm³ or significant bleeding), **IVIG** or **Corticosteroids** are first-line. * **Rule of Thumb:** Isolated thrombocytopenia + No Splenomegaly + Preceding URTI = ITP.
Explanation: ### Explanation The clinical presentation describes a classic case of **Chronic Benign Neutropenia of Childhood (CBNC)**. This condition is characterized by a persistent decrease in the absolute neutrophil count (ANC), typically between 500–1500 cells/mm³, in an otherwise healthy child who does not suffer from recurrent or severe infections. **1. Why "Watch and Wait" is Correct:** In CBNC, the bone marrow is cellular with normal maturation (as seen in this patient), and the neutropenia is often due to an increased peripheral destruction or a reduced marginating pool. Most children with this condition do not have an increased risk of serious bacterial infections because they can still mount an adequate neutrophilic response during acute stress or infection. The condition is self-limiting, usually resolving spontaneously by 2–4 years of age. Therefore, no active intervention is required other than clinical monitoring. **2. Why Other Options are Incorrect:** * **A. Corticosteroids:** These are used for autoimmune neutropenia if there are life-threatening infections, but they are not indicated in an asymptomatic child due to significant side effects. * **B. Multivitamins:** While B12 or folate deficiency can cause cytopenias, they usually present with macrocytic anemia and abnormal marrow findings, which are absent here. * **D. Prophylactic Antibiotics:** These are reserved for severe, symptomatic neutropenia (ANC <500) or specific primary immunodeficiencies. Overuse leads to antibiotic resistance and is unnecessary in a healthy child. **Clinical Pearls for NEET-PG:** * **Definition:** Neutropenia in children >1 year is ANC <1500/mm³. * **Benign Nature:** If the child is growing well and has no history of recurrent skin infections, abscesses, or stomatitis, the neutropenia is likely benign. * **Bone Marrow:** In CBNC, the marrow is typically normal or shows a "maturation arrest" at the promyelocyte/myelocyte stage, which is actually a normal finding in this context. * **Management:** Reassurance and observation are the cornerstones of management for asymptomatic mild-to-moderate neutropenia.
Explanation: **Explanation:** The correct answer is **Copper deficiency** because it typically presents as a **microcytic, hypochromic anemia** (mimicking iron deficiency) or a normocytic anemia, often accompanied by neutropenia. Copper is a vital cofactor for *hephaestin* and *ceruloplasmin*, enzymes required for iron transport and utilization. Its deficiency leads to impaired iron incorporation into hemoglobin, resulting in small red blood cells rather than large ones. **Analysis of other options:** * **Thiamine deficiency (Option A):** Specifically, **Thiamine-Responsive Megaloblastic Anemia (TRMA)** or Rogers Syndrome is a rare genetic disorder characterized by megaloblastic (macrocytic) anemia, non-type 1 diabetes, and sensorineural deafness. * **Orotic aciduria (Option B):** This is an autosomal recessive disorder of pyrimidine synthesis. The deficiency of UMP synthase leads to a failure in DNA synthesis, resulting in a **megaloblastic (macrocytic) anemia** that does not respond to Vitamin B12 or Folic acid. * **Liver disease (Option C):** Chronic liver disease causes macrocytosis through several mechanisms, including increased lipid deposition on the RBC membrane (target cells) and altered cholesterol metabolism, leading to an increased Mean Corpuscular Volume (MCV). **High-Yield Clinical Pearls for NEET-PG:** 1. **Copper Deficiency Hallmark:** Look for the combination of **anemia + neutropenia** in a patient on long-term TPN or following gastric bypass surgery. 2. **Bone Marrow Finding:** Copper deficiency often shows **ringed sideroblasts** and cytoplasmic vacuolization in myeloid precursors, which can be mistaken for Myelodysplastic Syndrome (MDS). 3. **Macrocytic Anemia Classification:** Always differentiate between **Megaloblastic** (DNA synthesis defect: B12/Folate deficiency, Orotic aciduria) and **Non-megaloblastic** (Liver disease, Hypothyroidism, Diamond-Blackfan anemia).
Explanation: **Explanation:** The clinical presentation is classic for **Immune Thrombocytopenic Purpura (ITP)**, the most common cause of isolated thrombocytopenia in children. **1. Why ITP is the correct answer:** * **Acute Onset:** ITP typically presents with the sudden appearance of petechiae, purpura, or bruising in an otherwise healthy child ("overnight" onset). * **Preceding Trigger:** About 60% of cases follow a viral infection (respiratory or gastrointestinal, explaining the abdominal pain two weeks prior) by 1–4 weeks. * **Negative Findings:** The **absence of hepatosplenomegaly** and lymphadenopathy is a crucial diagnostic pointer, as it suggests a peripheral destruction of platelets rather than a bone marrow infiltrative process. **2. Why other options are incorrect:** * **Acute Lymphoblastic Leukemia (ALL):** While ALL causes petechiae, it usually presents with systemic symptoms (fever, bone pain) and physical findings like hepatosplenomegaly or lymphadenopathy. * **Aplastic Anemia:** This involves pancytopenia. Patients would typically present with pallor (anemia) and increased susceptibility to infections (leukopenia) alongside bleeding, usually with a more insidious onset. * **Acute Viral Infection:** While a viral infection can cause mild thrombocytopenia, the dramatic "overnight" appearance of petechiae after the infection has resolved points specifically to the post-viral immune-mediated destruction seen in ITP. **Clinical Pearls for NEET-PG:** * **Diagnosis of Exclusion:** ITP is diagnosed by isolated thrombocytopenia (Platelets <100,000/µL) with normal hemoglobin and WBC counts. * **Bone Marrow:** Not routinely required unless atypical features are present; if done, it shows **increased megakaryocytes**. * **Management:** Most childhood cases are self-limiting. If treatment is needed (due to mucosal bleeding), **IVIG** or **Corticosteroids** are first-line. * **Prognosis:** 80% of children recover spontaneously within 6 months.
Explanation: ### Explanation **1. Why Physiological Anemia is the Correct Answer:** Physiological anemia of infancy is a normal, non-pathological drop in hemoglobin (Hb) levels that occurs in healthy, term infants. After birth, the transition from a low-oxygen intrauterine environment to a high-oxygen extrauterine environment leads to a surge in tissue oxygenation. This causes a **downregulation of Erythropoietin (EPO)** production by the kidneys, leading to a temporary suspension of erythropoiesis. Additionally, the shortened lifespan of neonatal red blood cells (60–90 days) and rapid expansion of blood volume contribute to this decline. In term infants, the Hb nadir typically reaches **9–11 gm% at 6–9 weeks of age**, which matches this clinical presentation. **2. Why Other Options are Incorrect:** * **Pathological Anemia:** This is suggested if the Hb drop occurs earlier (first 4 weeks), is more severe (<9 gm%), or is accompanied by jaundice, hepatosplenomegaly, or reticulocytosis. * **Thalassemia:** While a common cause of microcytic anemia, β-thalassemia major usually presents later (after 6 months) as fetal hemoglobin (HbF) transitions to adult hemoglobin (HbA). * **Iron Deficiency Anemia (IDA):** Term infants have sufficient iron stores for the first 4–6 months of life. IDA is rare at 6 weeks unless there was significant perinatal blood loss or extreme prematurity. **3. NEET-PG High-Yield Pearls:** * **Nadir Timing:** Term infants reach nadir at **6–9 weeks** (Hb ~9–11 gm%); Preterm infants reach nadir earlier at **4–8 weeks** (Hb ~7–9 gm%). * **Management:** No treatment is required for physiological anemia; it resolves spontaneously as EPO levels rise in response to the lower Hb. * **Iron Stores:** Iron supplementation in term infants is generally started at **4 months** of age to prevent late-onset IDA.
Explanation: ### Explanation **Correct Answer: C. Insertion** **The Concept:** The genetic code is read in sets of three nucleotides called **codons**. A **frameshift mutation** occurs when the number of nucleotides added (insertion) or removed (deletion) is not a multiple of three. This shifts the "reading frame" of the mRNA during translation. Consequently, every single amino acid downstream of the mutation is altered, often leading to a premature stop codon and a non-functional, truncated protein. **Analysis of Options:** * **Insertion (Correct):** Adding one or two nucleotides disrupts the triplet reading frame, causing a frameshift. (Note: Deletion also causes this). * **Transition (Incorrect):** This is a type of point mutation where a purine is replaced by a purine (A↔G) or a pyrimidine by a pyrimidine (C↔T). It changes only one codon. * **Transversion (Incorrect):** A point mutation where a purine is replaced by a pyrimidine or vice versa (e.g., A↔C). Like transitions, these are "substitutions" and do not shift the reading frame. * **Point Mutation (Incorrect):** This is a broad term for a change in a single nucleotide base pair. While it includes insertions, it most commonly refers to substitutions (silent, missense, or nonsense mutations) which do not necessarily cause a frameshift. **High-Yield Clinical Pearls for NEET-PG:** * **Duchenne Muscular Dystrophy (DMD):** Classically caused by **frameshift mutations** (deletions), leading to a complete absence of functional dystrophin. * **Becker Muscular Dystrophy (BMD):** Caused by **non-frameshift mutations** (in-frame deletions); the protein is shorter but partially functional, resulting in a milder phenotype. * **Tay-Sachs Disease:** Often results from a 4-base pair insertion in the HEXA gene, causing a frameshift. * **Beta-Thalassemia:** Can be caused by various mutations, including frameshifts that result in "null" ($\beta^0$) production of globin chains.
Explanation: ### Explanation **Correct Answer: A. Fanconi Anemia** **Reasoning:** The clinical triad of **short stature**, **café-au-lait spots**, and **aplastic anemia** (suggested by the "dry tap" or fat-rich bone marrow) is classic for **Fanconi Anemia (FA)**. FA is the most common cause of inherited bone marrow failure. It is an autosomal recessive (mostly) DNA repair defect. * **Physical Findings:** Short stature, skin hyperpigmentation (café-au-lait spots), and skeletal anomalies (especially **absent/hypoplastic thumb** or radius). * **Hematology:** Progressive pancytopenia usually manifests between ages 2 and 10. The bone marrow biopsy typically shows **hypocellularity with fatty replacement**, as described in the question. **Why other options are incorrect:** * **B. Dyskeratosis Congenita:** While it also causes inherited bone marrow failure, it is characterized by a specific clinical triad: **abnormal skin pigmentation (reticular), nail dystrophy, and oral leukoplakia**. * **C. Tuberous Sclerosis:** Presents with café-au-lait spots and skin lesions (ash-leaf spots, adenoma sebaceum), but it is a neurocutaneous syndrome associated with seizures and tumors (hamartomas), not bone marrow failure. * **D. Osteogenesis Imperfecta:** Characterized by bone fragility, blue sclera, and hearing loss; it does not present with aplastic anemia or café-au-lait spots. **High-Yield Clinical Pearls for NEET-PG:** * **Gold Standard Test:** Chromosomal breakage analysis using **Diepoxybutane (DEB)** or Mitomycin C. * **Malignancy Risk:** Patients have a significantly increased risk of **AML** and squamous cell carcinomas (head, neck, and anogenital). * **Most common skeletal deformity:** Thumb and radial ray defects. * **Treatment of choice:** Hematopoietic stem cell transplant (HSCT).
Anemias in Children
Practice Questions
Hemoglobinopathies
Practice Questions
Hemolytic Anemias
Practice Questions
Nutritional Anemias
Practice Questions
Thrombocytopenia
Practice Questions
Bleeding Disorders
Practice Questions
Thrombotic Disorders
Practice Questions
White Blood Cell Disorders
Practice Questions
Bone Marrow Failure Syndromes
Practice Questions
Blood Component Therapy
Practice Questions
Hemophilia and Von Willebrand Disease
Practice Questions
Evaluation of Bleeding Tendencies
Practice Questions
Get full access to all questions, explanations, and performance tracking.
Start For Free